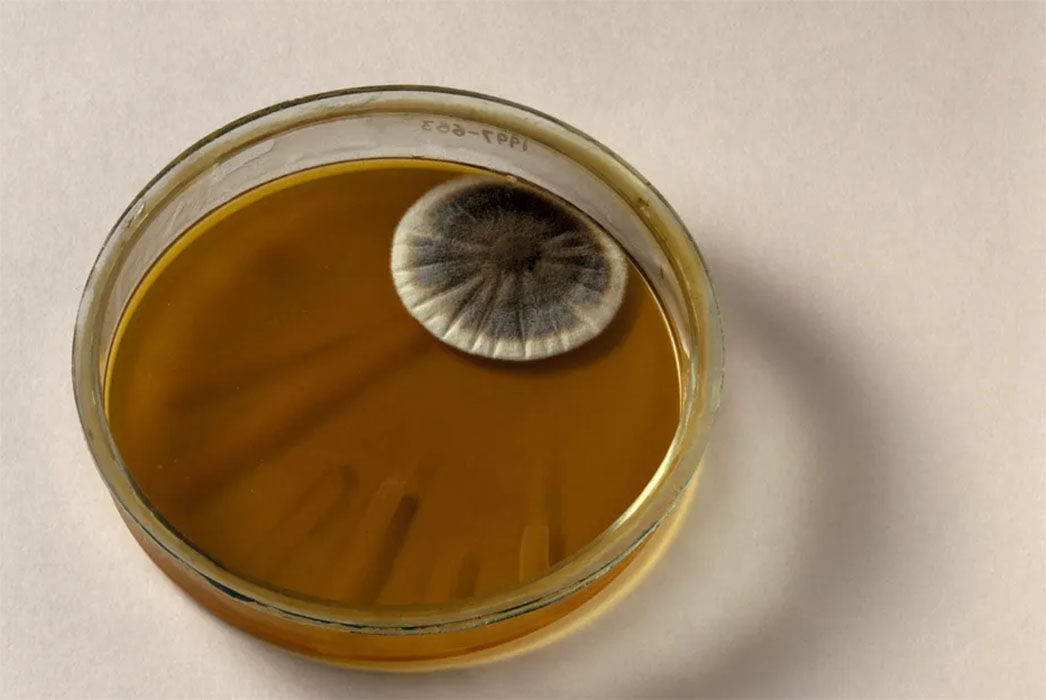

97 Tahun Lalu, Alexander Fleming Tak Sengaja Temukan Penisilin dan Selamatkan Setengah Miliar Orang
- Alexander Fleming sedang melakukan eksperimen dengan bakteri ketika ia terbangun dan mendapati jamur aneh tumbuh di cawan petrinya. "Sari jamur" tersebut akan menjadi awal mula antibiotik pertama, penisilin, dan merevolusi perawatan medis untuk infeksi bakteri.

Amirudin Zuhri
Author


JAKARTA, TRENASIA.ID-Pada 28 September 1928, Alexander Fleming bangun untuk memeriksa eksperimennya yang menyelidiki pertumbuhan bakteri dan secara tidak sengaja menemukan antibiotik pertama di dunia.
Fisikawan dan mikrobiolog asal Skotlandia ini telah melakukan eksperimen di sebuah ruangan sempit seluas kurang lebih 1 meter persegi di sebuah menara di Rumah Sakit St. Mary London. Ilmuwan yang terkenal ceroboh ini akan membudidayakan bakteri dari pasien rumah sakit yang terinfeksi.
Dia akan membiarkan kultur tersebut selama dua atau tiga minggu hingga meja kerjanya penuh dengan 40 hingga 50 lempeng . Kemudian, ia akan memeriksa setiap lempeng untuk melihat apakah ada sesuatu yang menarik yang tumbuh di dalamnya, sebelum membuangnya.
Penemuan penisilin terjadi ketika Fleming kembali dari cuti dua minggu. Ia mengamati cawan Staphylococcus aureus miliknya yang telah dikultur dari luka yang terinfeksi. Pada salah satu cawan, Fleming melihat bercak jamur hijau yang berpotongan dengan koloni bakteri berwarna kuning keemasan, menurut keterangan dari asistennya, VD Allison.
Di dekat bercak hijau tersebut, bakteri tersebut tampak transparan, tidak berwarna, dan mati. Zat yang membunuh bakteri tersebut akan menjadi dasar antibiotik pertama, meskipun istilah tersebut baru diciptakan pada tahun 1941 .
"Ketika saya bangun tepat setelah fajar pada tanggal 28 September 1928, saya tentu saja tidak berencana untuk merevolusi seluruh dunia kedokteran dengan menemukan antibiotik atau pembunuh bakteri pertama di dunia," kata Fleming kemudian. "Tapi saya rasa itulah yang saya lakukan."
Fleming memastikan bahwa "cairan jamur" tersebut berasal dari spesies jamur yang akhirnya ia identifikasi sebagai Penicillium . Ketika ia menjelaskan penemuan tersebut kepada rekan-rekan dokternya di sebuah pertemuan tahun berikutnya, ia disambut dengan ketidakpedulian yang hampir total.
“Mengisolasi ‘cairan jamur’ yang sulit dipahami tersebut juga terbukti menantang, sehingga penemuan tersebut terbengkalai selama satu dekade, tulis Allison dalam kenangan pribadinya.
- Baca juga: Mengkhawatirkan, Beberapa Antibiotik Kehilangan Efektivitas Mengobati Infeksi Bakteri pada Anak
Kemudian, pada tahun 1939, ilmuwan Howard Florey dan Ernst Chain tertarik pada zat tersebut. Mereka membentuk tim peneliti dan, bersama ilmuwan seperti Margaret Jennings, Edward Abraham, dan Norman Heatley, berhasil mengisolasi penisilin dari jamur, mengujinya, dan menggunakan zat berwarna kuning seperti bubuk tersebut untuk menyembuhkan beberapa pasien. Namun, senyawa tersebut masih relatif tidak murni.
Pada tahun 1942, Fleming sedang merawat seorang pasien muda yang menderita meningitis parah . Ia menemukan bubuk tersebut mampu membunuh infeksi bakteri pasien tersebut, dan ia menelepon Florey dan Chain untuk meminta sebagian dari simpanan mereka, meskipun bubuk tersebut belum dimurnikan.
Setelah Fleming menyuntikkannya ke sumsum tulang belakang anak laki-laki itu, pasien tersebut pulih. Setelah pemulihan ajaib ini, Fleming yakin bahwa penisilin perlu diproduksi massal.
Ia mengajukannya kepada pemerintah, dan tak lama kemudian, Amerika Serikat dan Inggris bekerja sama untuk memproduksi zat tersebut secara massal. Pada tahun 1945, antibiotik pertama tersedia secara luas.
Fleming, Florey, dan Chain memenangkan Hadiah Nobel Kedokteran tahun 1945 atas karya mereka dalam penemuan, isolasi, dan produksi penisilin. Pada tahun 1964, Dorothy Hodgkin meraih Hadiah Nobel Kimia atas keberhasilannya dalam menjelaskan struktur kristal penisilin, yang membantu para ahli kimia merancang antibiotik di kemudian hari.
Baca juga: Tahukah Anda, Bubuk Mesiu Ditemukan Saat Orang Mencari Ramuan Keabadian
Sebagaimana dikutip dari Live Science, diperkirakan sejak penemuannya, penisilin telah menyelamatkan 500 juta jiwa. Bersama dengan turunannya, pinisilin masih menjadi andalan dalam pengobatan berbagai macam penyakit, termasuk infeksi telinga, radang tenggorokan , dan infeksi saluran kemih.
Penisilin juga mendorong pengembangan ratusan antibiotik yang berbeda . Namun, meluasnya penggunaan dan penyalahgunaan obat-obatan ajaib ini telah menyebabkan banyak strain bakteri mengembangkan resistensi terhadap antibiotik umum , termasuk penisilin.
Dalam perlombaan senjata melawan bakteri super, para ilmuwan kini menemukan cara-cara yang benar-benar baru untuk melawan bakteri, mulai dari memanfaatkan kekuatan virus untuk menyerang bakteri hingga menggunakan alat penyunting gen CRISPR untuk merancang obat baru.

Chrisna Chanis Cara
Editor
